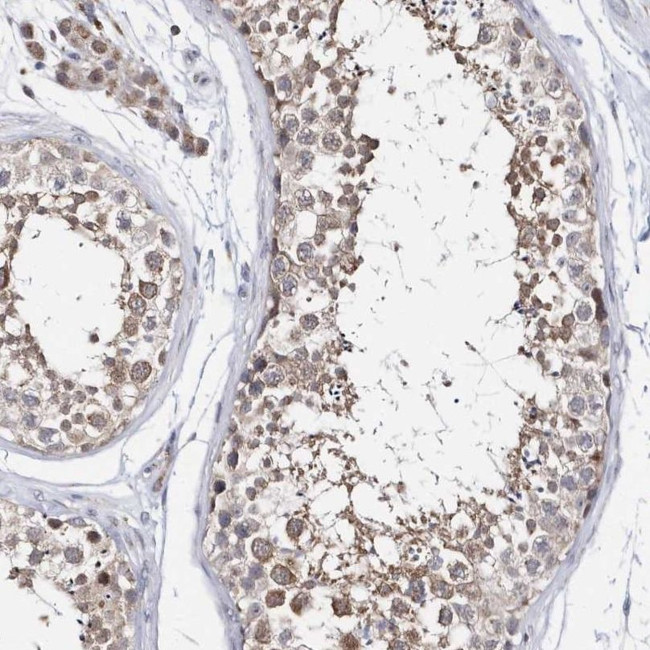
SPAT5 Antibody in Immunohistochemistry (IHC)

Search
Invitrogen
SPAT5 Polyclonal Antibody
{{$productOrderCtrl.translations['antibody.pdp.commerceCard.promotion.promotions']}}
{{$productOrderCtrl.translations['antibody.pdp.commerceCard.promotion.viewpromo']}}
{{$productOrderCtrl.translations['antibody.pdp.commerceCard.promotion.promocode']}}: {{promo.promoCode}} {{promo.promoTitle}} {{promo.promoDescription}}. {{$productOrderCtrl.translations['antibody.pdp.commerceCard.promotion.learnmore']}}
产品信息
PA5-57665
种属反应
宿主/亚型
分类
类型
抗原
偶联物
形式
浓度
规格
纯化类型
保存液
内含物
保存条件
运输条件
RRID
产品详细信息
Immunogen sequence: IQVQPLVGAV LQAEEMDVAL SDKDMEINEE ELTGCILRKL DGKIVLPGNF LYCTFYGRPY KLQVLRVKGA DGMILGGPQS DSDTDAQRMA
Highest antigen sequence identity to the following orthologs: Mouse - 83%, Rat - 81%.
靶标信息
This gene encodes a member of the ATPase associated with diverse activities family, whose members are defined by a highly conserved ATPase domain. Members of this family participate in diverse cellular processes that include membrane fusion, DNA replication, microtubule severing, and protein degradation. The protein encoded by this gene has a putative mitochondrial targeting sequence and has been proposed to function in maintenance of mitochondrial function and integrity during mouse spermatogenesis. Allelic variants in this gene have been associated with epilepsy, hearing loss, and cognitive disability syndrome. Alternative splicing results in multiple transcript variants.
仅用于科研。不用于诊断过程。未经明确授权不得转售。
篇参考文献 (0)
生物信息学
蛋白别名: AFG2 AAA ATPase homolog A; ATPase family gene 2 homolog; ATPase family gene 2 protein homolog A; ATPase family protein 2 homolog; Ribosome biogenesis protein SPATA5; SPAF; AAA-protein; spermatogenesis associated 5; spermatogenesis associated factor; spermatogenesis associated factor SPAF; Spermatogenesis-associated factor protein; Spermatogenesis-associated protein 5; unnamed protein product
基因别名: 2510048F20Rik; AFG2; AFG2A; C78064; EHLMRS; NEDHSB; SPAF; SPATA5
UniProt ID: (Human) Q8NB90, (Mouse) Q3UMC0
Entrez Gene ID: (Human) 166378, (Mouse) 57815, (Rat) 361935